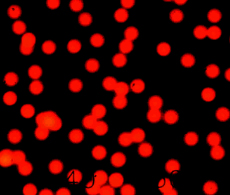

| 訂購號 | 產品描述: |
| R25 | Fluoro-Max 紅色熒光微粒溶液,0.025µm,1%固體,15ml |
| R25B | Fluoro-Max 紅色熒光微粒溶液,0.025µm,1%固體,90ml |
| R50 | Fluoro-Max 紅色熒光微粒溶液,0.050µm,1%固體,15ml |
| R50B | Fluoro-Max 紅色熒光微粒溶液,0.050µm,1%固體,90ml |
| R60 | Fluoro-Max 紅色熒光微粒溶液,0.060µm,1%固體,15ml |
| R60B | Fluoro-Max 紅色熒光微粒溶液,0.060µm,1%固體,90ml |
| R100 | Fluoro-Max 紅色熒光微粒溶液,0.10µm,1%固體,15ml |
| R100B | Fluoro-Max 紅色熒光微粒溶液,0.10µm,1%固體,90ml |
| R160 | Fluoro-Max 紅色熒光微粒溶液,0.16µm,1%固體,15ml |
| R160B | Fluoro-Max 紅色熒光微粒溶液,0.16µm,1%固體,90ml |
| R200 | Fluoro-Max 紅色熒光微粒溶液,0.20µm,1%固體,15ml |
| R200B | Fluoro-Max 紅色熒光微粒溶液,0.20µm,1%固體,90ml |
| R300 | Fluoro-Max 紅色熒光微粒溶液,0.30µm,1%固體,15ml |
| R300B | Fluoro-Max 紅色熒光微粒溶液,0.30µm,1%固體,90ml |
| R400 | Fluoro-Max 紅色熒光微粒溶液,0.40µm,1%固體,15ml |
| R400B | Fluoro-Max 紅色熒光微粒溶液,0.40µm,1%固體,90ml |
| R500 | Fluoro-Max 紅色熒光微粒溶液,0.50µm,1%固體,15ml |
| R500B | Fluoro-Max 紅色熒光微粒溶液,0.50µm,1%固體,90ml |
| R600 | Fluoro-Max 紅色熒光微粒溶液,0.60µm,1%固體,15ml |
| R600B | Fluoro-Max 紅色熒光微粒溶液,0.60µm,1%固體,90ml |
| R700 | Fluoro-Max 紅色熒光微粒溶液,0.70µm,1%固體,15ml |
| R700B | Fluoro-Max 紅色熒光微粒溶液,0.70µm,1%固體,90ml |
| R800 | Fluoro-Max 紅色熒光微粒溶液,0.80µm,1%固體,15ml |
| R800B | Fluoro-Max 紅色熒光微粒溶液,0.80µm,1%固體,90ml |
| R900 | Fluoro-Max 紅色熒光微粒溶液,0.90µm,1%固體,15ml |
| R900B | Fluoro-Max 紅色熒光微粒溶液,0.90µm,1%固體,90ml |
| R0100 | Fluoro-Max 紅色熒光微粒溶液,1.0µm,1%固體,10ml |
| R0100B | Fluoro-Max 紅色熒光微粒溶液,1.0µm,1%固體,60ml |
| R0200 | Fluoro-Max 紅色熒光微粒溶液,2.0µm,1%固體,10ml |
| R0200B | Fluoro-Max 紅色熒光微粒溶液,2.0µm,1%固體,60ml |
| R0300 | Fluoro-Max 紅色熒光微粒溶液,3.0µm,1%固體,10ml |
| R0300B | Fluoro-Max 紅色熒光微粒溶液,3.0µm,1%固體,60ml |
- ☆ ★~歡迎您到留言版給我們加油打氣~☆ ★
- ☆ ★~歡迎光臨本站~☆ ★
在比自身發散光波長短的激發光照射下,這種熒光微粒會發出明亮而清晰的顏色。相比較於背景材料,這大大提高了他們的對比度與可見度。
除了傳統顯微鏡的特點,熒光微粒為分析方法提供了更好的敏感性與可檢測性。這種熒光微粒是深度染色的(內部染色)聚合物微粒,它採用Firefli 合成方法將染料吸收入聚合物基質中。這種技術方法可產生明亮的熒光色,降低光褪色的可能性,並防止染料滲濾至液體介質中。
這種微粒由聚苯乙烯合成 (PS),密度為1.05 g/cm3 ,折射指數為1.59 @ 589nm (25°C)。懸浮液中含 1% 固體。
這些微粒可用落射熒光顯微鏡、共聚焦顯微鏡,熒光計、熒光分光光度儀,或熒光激活的細胞分類儀進行檢測。也可採用礦石燈或黑色光(UV)進行檢測。
這些光譜信息是近似值,僅供參考。這些染料的光譜特性有賴於它們的濃度與所處的物理環境。確切的激發光與最強發散光因微粒大小與成分的不同而不同。
技術參數:
成分: 聚苯乙烯
密度: 1.05 g/cm3
折射指數: 1.59 @ 589 nm (25°C)
添加劑: 含少量表面活性劑

Fluoro-Max Green Aqueous
Fluorescent Particles

Red Aqueous Fluorescent
Particles 
Fluoro-Max Blue Aqueous
Fluorescent Particles
|



.png)
.png)






.png)